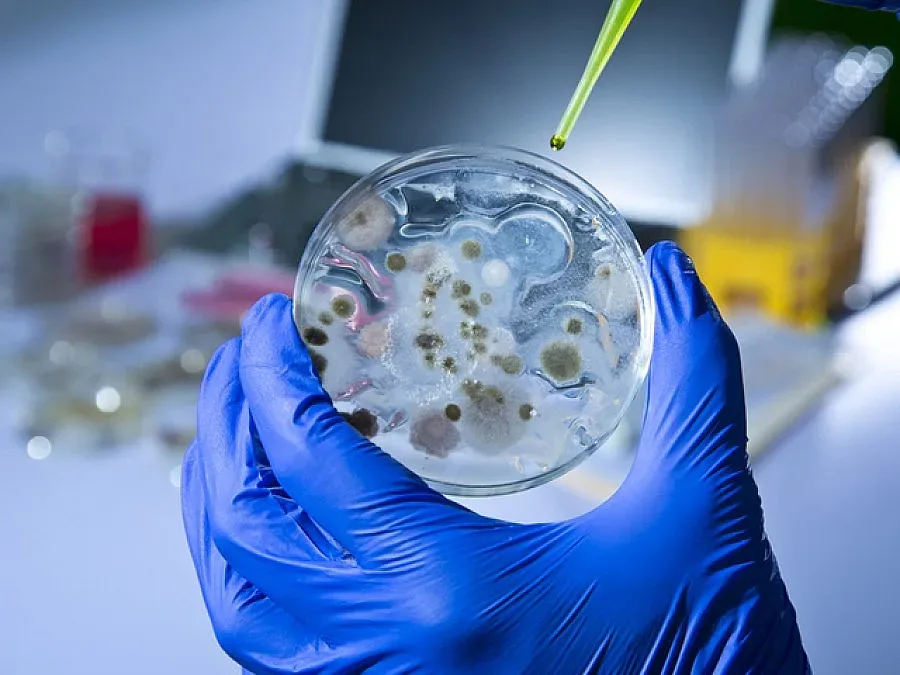
Антракс умори и бик от Млада гвардия

Почина и бик от варненското село Млада гвардия. Умрялото животно е от стадото на Марин Димитров, съсед на починалия от антракс Румен Стоянов. Той загуби преди седмица и бременна юница, за която резултатите потвърдиха, че е загинала от коварната зараза.Бикът е загробен на същото място, където и втората крава –в трап, предварително обработен със сода каустик. Бил е затворен, мястото е дезинфекцирано, няма опасност от зараза или заразено месо в търговската мрежа, увери временният шеф на Агенцията по безопасност на храните д-р Даниел Денев.От животното е взета проба след като станат известни резултатите, може да се каже, че се тръшнало от антракс. Стадото на бай Марин беше на пасбището с кравите на Румен стоянов, където се предполага, че след проливен дъжд е имало спори на антракс, които живеят над 70 години.Всички над 600 животни от Млада гвардия и още две стада от съседните две села Златина и Венчан също бяха ваксинирани срещу антракс и се очаква до края на седмицата да бъде изграден имунитетът им и да бъде вдигната карантината.
Последвайте ни в Google News Showcase за важните новини
Вижте всички актуални новини от Standartnews.com